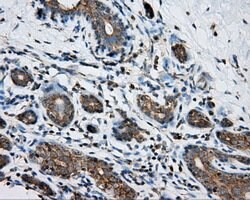
PRKAR2A Mouse anti-Human, Clone: OTI4A3, lyophilized, TrueMAB 100 &mu;g;

Learn More
PRKAR2A Mouse anti-Human, Clone: OTI4A3, lyophilized, TrueMAB™
Mouse Monoclonal Antibody
Brand: Origene Technologies CF501144

Description
Reconstitute with PBS (pH 7.3) and recommend to perform another round of desalting process using Product No. 7KMWCO
cAMP is a signaling molecule important for a variety of cellular functions. cAMP exerts its effects by activating the cAMP-dependent protein kinase (AMPK), which transduces the signal through phosphorylation of different target proteins. The inactive holoenzyme of AMPK is a tetramer composed of two regulatory and two catalytic subunits. cAMP causes the dissociation of the inactive holoenzyme into a dimer of regulatory subunits bound to four cAMP and two free monomeric catalytic subunits. Four different regulatory subunits and three catalytic subunits of AMPK have been identified in humans. The protein encoded by this gene is one of the regulatory subunits. This subunit can be phosphorylated by the activated catalytic subunit. It may interact with various A-kinase anchoring proteins and determine the subcellular localization of AMPK.Specifications
| PRKAR2A | |
| Monoclonal | |
| Unconjugated | |
| PRKAR2A | |
| PKR2, PRKAR2 | |
| Mouse | |
| Affinity Chromatography | |
| RUO | |
| 5576 | |
| -20° C, Avoid Freeze/Thaw Cycles | |
| Lyophilized |
| Immunocytochemistry, Immunofluorescence, Immunohistochemistry (Paraffin), Western Blot | |
| OTI4A3 | |
| PBS with 8% trehalose and no preservative; pH 7.3 | |
| P13861 | |
| PRKAR2A | |
| Full length human recombit protein of human PRKAR2A produced in HEK293T cell. | |
| 100 μg | |
| Primary | |
| Human | |
| Antibody | |
| IgG1 |
The Fisher Scientific Encompass Program offers items which are not part of our distribution portfolio. These products typically do not have pictures or detailed descriptions. However, we are committed to improving your shopping experience. Please use the form below to provide feedback related to the content on this product.